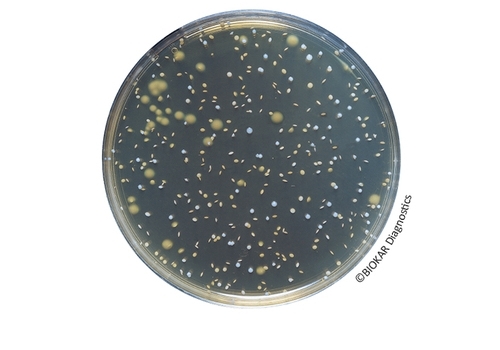
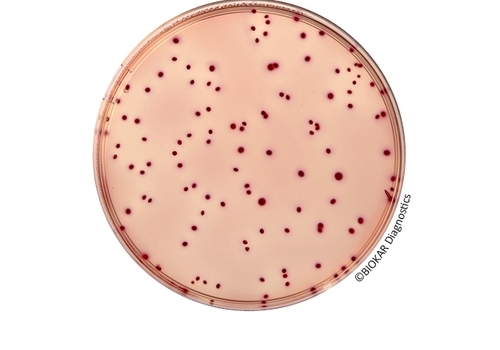
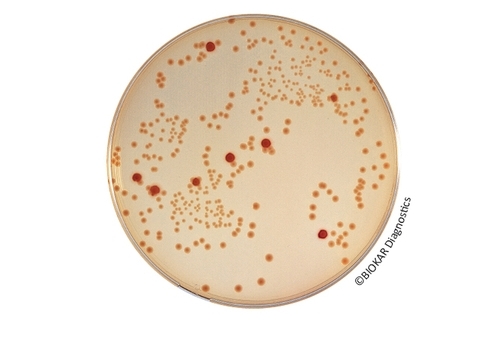

Biokar Diagnostics
Biokar Diagnostics is the microbiology division of the Solabia group, dedicated to the development, production and selling of culture media, supplements and detection kits for microbiology laboratories. Biokar Diagnostics offers more than 40 years of experience in microbiology, in sectors as varied as:
→ Agro food industries
→ Cosmetic industries
→ Pharmaceutical industries
→ Water and environmental
→ Animal health
→ Research institutions and education
With over 300 products and a presence in over 40 countries, BIOKAR Diagnostics has acquired an international reputation for the quality of his products and innovative solutions.
Quality
All our products and reagents are subject to a quality control plan according to the EN ISO 11133 standard published in January 2015 and FD T90-461 published in August 2016. BIOKAR Diagnostics performs strict controls to each manufacturing step, targeting the raw materials, in-process intermediate products and the final end product. All production batches are released for sale only when they meet or exceed pre-defined acceptation criteria (microbiological performance, stability, pH,…). In case of need, a sample is kept for reference in a sample collection for each batch for duration of its validity.
We cary out rigorous controls at each stage of manufacture on raw materials, in-process intermediate products and the final end product. Our quality system is ISO 9001 for the production of culture media and reagents for laboratories. Our culture media are sompliant with current standards and our innovative products are validated by AFNOR Certification.
Biokar Product Range
With over 300 product references, we offer a large range of culture media and packaging:
- Dehydrated culture media
- Agar media
- Liquid media
- Supplements and additives
- Kits
- Reagents and accessories
Environmental Policy
We conduct regular audits to assess and reduce our environmental impact. Our actions have already resulted in:
- Recycling our waste cardboard and plastic.
- Improvement of consumption of water and energy in our production sites.
- Use of 100% recycled and 100% recyclable material for our packaging.
Technical Supports
We provide technical supports:
- Product presentations: IRIS Salmonella® , RHAPSODY®, COMPASS® Listeria, COMPASS® Bacillus, EASY Staph®
- Media operating handbook
Technical Library
Access directly to all our Technical Data Sheets (TDS) and Material Safety Data Sheets (MSDS) from product pages.
Quality Control Certificate
Access directly to the Quality Control Certificates (QCC) of products that you ordered, using product code and lot number on Biokar web site www.biokar-diagnostics.com

Escherichia coli
Escherichia coli The presence of coliform bacilli and E.coli in particular is an indicator of..
More

Listeria
Listeria Listeria is a gram-positive rod-shaped bacterium that can grow under either..
More
Pseudomonas
Pseudomonas Pseudomonas are ubiquitous. They can be found in water and soil as well as on and in..
More

Salmonella
Salmonella Salmonella species are Gram-negative, flagellated facultatively anaerobic..
More





Yeasts and molds
Yeasts and molds Just like certain bacteria, yeasts and moulds play an important role in the..
More
Enterococci
Enterococci Enterococci, which were formerly classified as streptococci, play an important role..
More

Lactic Bacteria
Lactic Bacteria Lactic acid bacteria are a heterogeneous group of anaerobic, but usually..
More
Escherichia coli O157
Escherichia coli O157 E.coli are a large and diverse group of bacteria. Although most strains of..
More